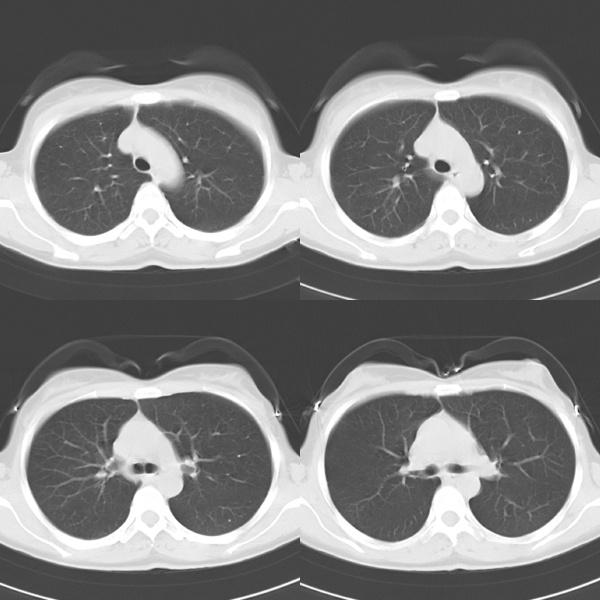
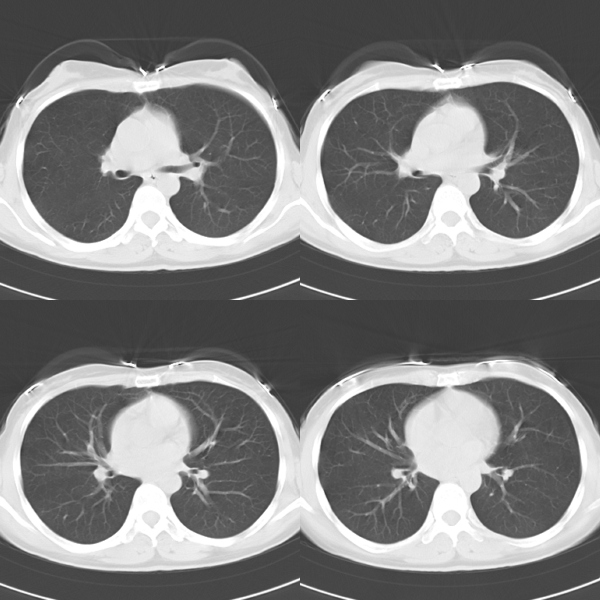
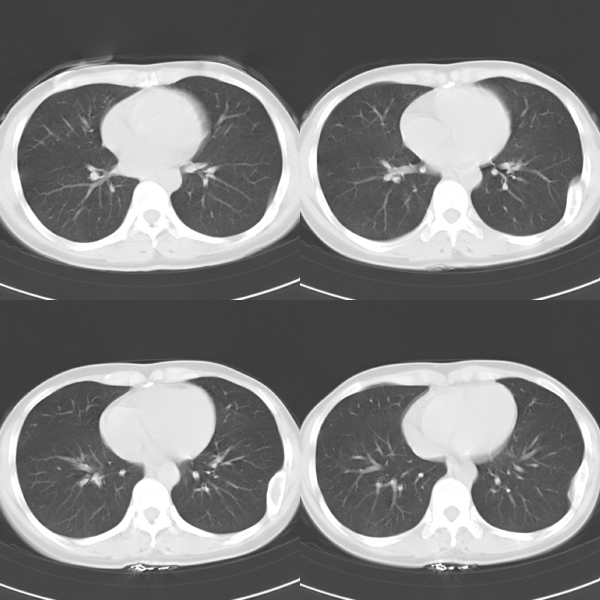

医影在线
标题: CT19623:F40y,肋骨改变。 [打印本页]
作者: lczeng 时间: 2009-4-27 22:07
标题: CT19623:F40y,肋骨改变。
40岁女性,双侧胸部疼痛,以左侧为明显1+年。余无明显异常。

[本贴已被 lczeng 于 2009-4-27 14:12:55 修改过]
[本贴已被 翁志蓬 于 2009-4-27 23:18:30 修改过]
作者: 深泽交通 时间: 2009-4-27 22:44
骨纤可能
作者: 小康 时间: 2009-4-27 22:47
考虑骨纤
作者: 随光逐影 时间: 2009-4-28 00:04
考虑左侧肋骨骨纤维异常增殖症。
作者: ct诊断高手 时间: 2009-4-28 00:06
骨纤可能
作者: 37度 时间: 2009-4-28 00:27
骨纤。
作者: 沉默是金 时间: 2009-4-28 00:46
考虑骨纤
作者: scdlc2008 时间: 2009-4-28 00:52
考虑骨纤
作者: zxl51642 时间: 2009-4-28 00:53
骨纤维异常增殖症。
作者: yuhongjun 时间: 2009-4-28 00:57
考虑左侧肋骨骨纤维异常增殖症。
作者: qxhxf 时间: 2009-4-28 01:16
左侧肋骨骨纤维异常增殖症,
骨囊肿?
作者: 道哥 时间: 2009-4-28 01:21
左侧肋骨单发膨胀性病变,皮质连续,病史较长,首先考虑良性病变:骨纤可能性大。
作者: 同 时间: 2009-4-28 01:44
考虑 骨纤维异常增殖症。
作者: wsz9999 时间: 2009-4-28 01:47
考虑左侧肋骨骨纤维异常增殖症。
作者: dr.yang 时间: 2009-4-28 02:04
考虑左侧肋骨骨纤维异常增殖症。
作者: 不学无术 时间: 2009-4-28 04:33
考虑左侧肋骨骨纤维异常增殖症可能
作者: 黑白光影 时间: 2009-4-28 06:02
左侧肋骨骨纤维异常增殖症可能。
作者: LIAOQIANG 时间: 2009-4-28 17:44
考虑左侧肋骨骨纤维异常增殖症可能。
作者: dr.yang 时间: 2012-6-24 16:50
再次学习
作者: wansheng 时间: 2012-6-24 22:51
考虑左侧肋骨骨纤维异常增殖症。 支持
| 欢迎光临 医影在线 (http://bbs.radida.com/bbs/) |
Powered by Discuz! X3.2 |